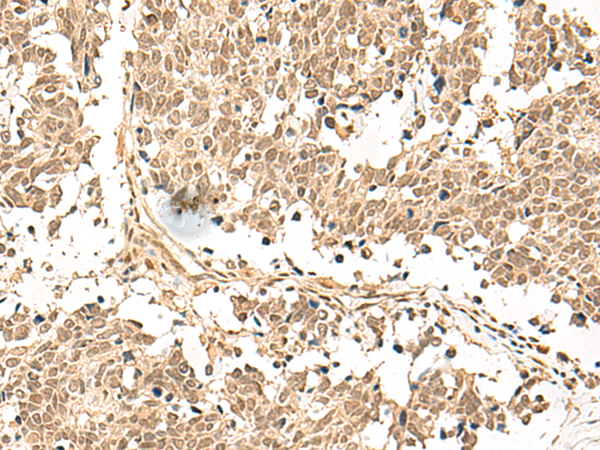

|
Background: |
This gene encodes a member of the F-box protein family, which are characterized by an approximately 40 amino acid motif, the F-box. F-box proteins constitute one subunit of modular E3 ubiquitin ligase complexes, called SCF complexes, which function in phosphorylation-dependent ubiquitination. The F-box domain mediates protein-protein interactions and binds directly to S-phase kinase-associated protein 1. In addition to an F-box domain, the encoded protein contains at least 9 tandem leucine-rich repeats. The ubiquitin ligase complex containing the encoded protein may function in cell-cycle control by regulating levels of lysine-specific demethylase 4A. Alternative splicing results in multiple transcript variants. |
|
Applications: |
ELISA, WB, IHC |
|
Name of antibody: |
FBXL4 |
|
Immunogen: |
Synthetic peptide of human FBXL4 |
|
Full name: |
F-box and leucine rich repeat protein 4 |
|
Synonyms: |
FBL4; FBL5; MTDPS13 |
|
SwissProt: |
Q9UKA2 |
|
ELISA Recommended dilution: |
5000-10000 |
|
IHC positive control: |
Human ovarian cancer and Human lung cancer |
|
IHC Recommend dilution: |
30-150 |
|
WB Predicted band size: |
70 kDa |
|
WB Positive control: |
LOVO cell lysate |
|
WB Recommended dilution: |
200-1000 |

購物車
購物車 幫助
幫助
 021-54845833/15800441009
021-54845833/15800441009
